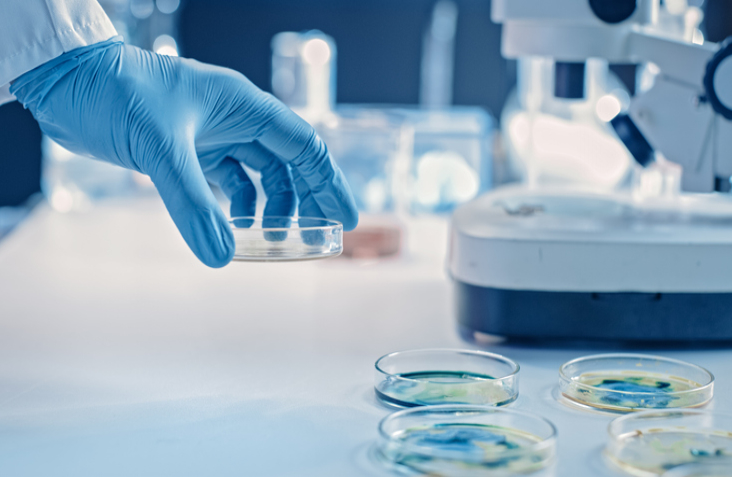

The disease
Mutations in the GNAO1 gene of the G203R variant are the most aggressive form of the disease. Patients diagnosed with this variant experience the full spectrum of symptoms associated with the disease: from seizures to movement disorders of different types.